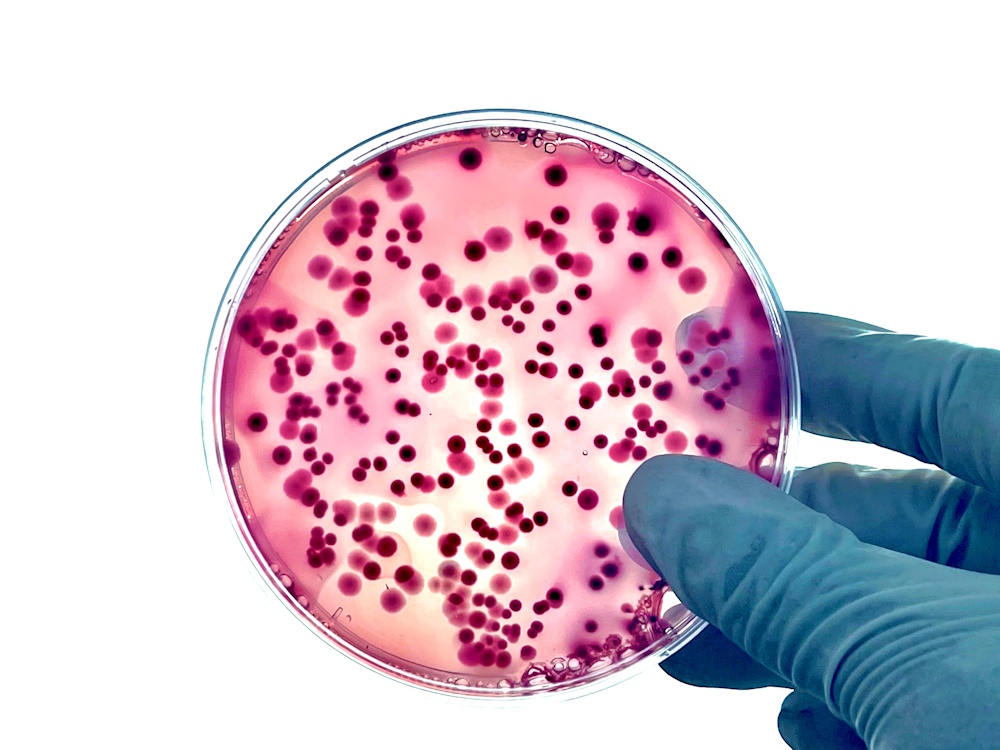
Equipment & Vehicle News: Diesel Fuel Contamination Will Cost You

1 min read
Diesel Fuel Tank Corrosion: A New Culprit
Ever since the EPA mandated the introduction of ultra-low sulfur diesel (ULSD), fueling stations and stored fuel users have been consistently...
2 min read
Bell Performance : Sep 1 2011

Like it or not, diesel fuel begins to deteriorate as soon as it is produced. This deterioration does not present a major problem if the fuel is consumed relatively quickly. However, diesel fuel may be stored for months or even years in places like standby systems. The ensuing deterioration of the fuel not only affects pumpability and combustibility, but it most likely may cause engine damage.
Estimates are that eight out of every ten diesel engine failures have been directly related to contaminated fuel. Contaminants in the fuel storage tanks can quickly clog filters, resulting in engine shut down, fuel pump wear, and diesel engine damage. These situations are both time-consuming and costly.
Estimates are that eight out of every ten diesel engine failures have been directly related to contaminated fuel. Contaminants in the fuel storage tanks can quickly clog filters, resulting in engine shut down, fuel pump wear, and diesel engine damage. These situations are both time-consuming and costly.
You can buy the most expensive, state of the art equipment, but without clean, good grade fuel it cannot do its job. Storing diesel fuel in tanks for later use or fuel in tanks of vehicles not used immediately is asking for trouble, due to the microbes (bacteria) and fungi that grow and thrive on water buildup in the tanks. How quickly the “bugs” turn fresh fuel into sludge-and-slime-filled fuel depends on factors such as climate, weather, tank conditions, or tank design.
What can you expect if this problem develops? Clogged fuel lines, filters, and damaged engines. In the tanks themselves, as the bacteria and fungi develop, the slime they create sticks to the walls of the tanks and begins a corrosion process that can also lead to tank damage and possible fuel leakage into the ground. Water buildup doesn’t just contribute to microbial contamination. While gasoline acts as a fuel only, diesel fuel must also function to cool and lubricate injection system parts. These parts are engineered to very close tolerances up to 0.0002 of an inch and any contamination means rapid wear or seizure of components. Water not only displaces the diesel fuel; it acts as a cutting agent, scoring these parts. In either case, costly damages are the inevitable result.
Water that makes it to the brink of entry into the combustion chamber results in even more serious damage. When it comes in contact with the heat of the combustion chamber and the injector tip (which can be in excess of 2,000 degrees F), it immediately turns to steam and often literally explodes the tip of the injector resulting in some very expensive repairs
These problems can be avoided if you follow some simple preventive maintenance procedures, such as limiting water buildup in storage tanks through the use of DFS Plus and regular treatments with a quality biocide like Bell Performance Bellicide to kill the existing microorganisms. Continual use of Bell Performance’s multi-function diesel treatment Dee-Zol will also control and limit the amount of water that ends up in diesel fuel, as well as improve combustion (and fuel usage rates), slow down the deterioration of the fuel and lubricate internal fuel system components to keep them in good working order.

1 min read
Ever since the EPA mandated the introduction of ultra-low sulfur diesel (ULSD), fueling stations and stored fuel users have been consistently...
1 min read
One of our most popular webinars from the past dealt with such an important issue - Diesel Fuel Storage Tank Corrosion - that we thought it was...
1 min read
Data center operators invest millions in redundant power systems, yet many overlook the most critical component sitting in their fuel tanks: the...